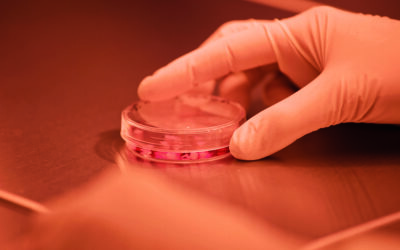
Crianças com paralisia cerebral melhoram após tratamento com sangue do cordão umbilical de um irmão

A atividade física e o contacto com a natureza tornam as crianças mais felizes e ajudam a diminuir os efeitos negativos resultantes de tempos prolongados nos ecrãs, relata artigo na revista The Lancet Child and Adolescent Health.
Notícias //
Nutrição na gravidez afeta saúde infantil a longo prazo
A obesidade antes e durante a gravidez aumenta o risco nas crianças de desenvolverem dificuldades cognitivas e comportamentais à medida que crescem, alerta estudo no JAMA Network Open.
Novas regras para alimentos à venda nas escolas
Governo criou restrições nos alimentos que se podem vender nas escolas. Conheça as listas de produtos alimentares que podem ou não ser disponibilizados nos bufetes escolares e máquinas de venda já a partir do próximo ano letivo.
Crianças com paralisia cerebral melhoram após tratamento com sangue do cordão umbilical de um irmão
Segundo os resultados de um ensaio clínico de fase 1, desenvolvido por investigadores da Universidade de Duke, nos EUA.
Bebés amamentados têm tensão arterial mais saudável aos três anos de idade
Especialistas apontam também que a pressão sanguínea mais baixa numa idade precoce contribui para um coração e vasos sanguíneos mais saudáveis na idade adulta.
DGS alerta para temperaturas elevadas
Proteja-se do calor e siga os conselhos da Direção-Geral de Saúde para enfrentar as atuais altas temperaturas. Grávidas, bebés e crianças são grupos vulneráveis.
Dicionário de saúde
As causas, os sintomas e os tratamentos das doenças mais comuns nas crianças
SUBSCRIÇÃO DE NEWSLETTER
Preencha o formulário e escolha a lista de envio pretendida.
Opinião //
Gravidez //
O sono e a fadiga durante a gravidez
Para grande parte das mulheres, a gravidez é um momento de alegria, emoção e expectativa. Porém, também é uma altura de grandes perturbações a nível do sono.
O “teste do pezinho”
Saiba mais sobre o teste que permite identificar as crianças que sofrem de doenças, quase sempre genéticas, de forma a beneficiarem de um tratamento precoce.
Nutrir bem o corpo na gravidez
Uma alimentação adequada permite o bem-estar da futura mãe e o crescimento do bebé no útero. Siga as principais boas práticas e recomendações alimentares.
Bebé //
Check-list para viajar com bebés e crianças
Fique com uma lista dos acessórios essenciais para fazer viagens com crianças, antecipando imprevistos e contribuindo para um maior conforto.
Como preparar o banho do bebé
A higiene deve ser um momento agradável para o bebé. Fique a conhecer os cuidados a ter com o banho desde o nascimento.
Superpoderes dos vegetais
Fique com uma seleção de legumes para variar a oferta alimentar do bebé. Saiba mais sobre as principais propriedades e dicas de confeção.
Superpoderes das frutas
A maçã, a pera e a banana são as primeiras frutas a entrar na dieta do bebé . Fique com uma seleção de frutas para diversificar sabores.
Criança //
É urgente: toca a ler!
É ideia geral que as crianças e os jovens cada vez leem menos. Livros “a sério” estão a cair em desuso, para lá dos que os professores de Português impõem nas aulas.
Conviver com os avós em tempos de pandemia
Isabel Alçada salienta a importância de as famílias se adaptarem à pandemia. Muitos avós aprenderam a usar as tecnologias para conviver com os netos.
12 Ideias para estimular a criatividade do seu filho
Veja a fotogaleria com dicas práticas para os pais encorajarem (ainda mais) o lado criativo dos mais pequenos.
Como gerir o tempo de ecrã do seu filho
Pais e especialistas apontam que o uso de ecrãs traz vantagens e desvantagens para as crianças. Conheça as boas práticas recomendadas para uma utilização segura e em linha com as orientações mais atuais.
Alimentar o bebé
Aprenda a selecionar e a introduzir os alimentos de forma segura e saudavel na dieta do seu filho.
Pais //